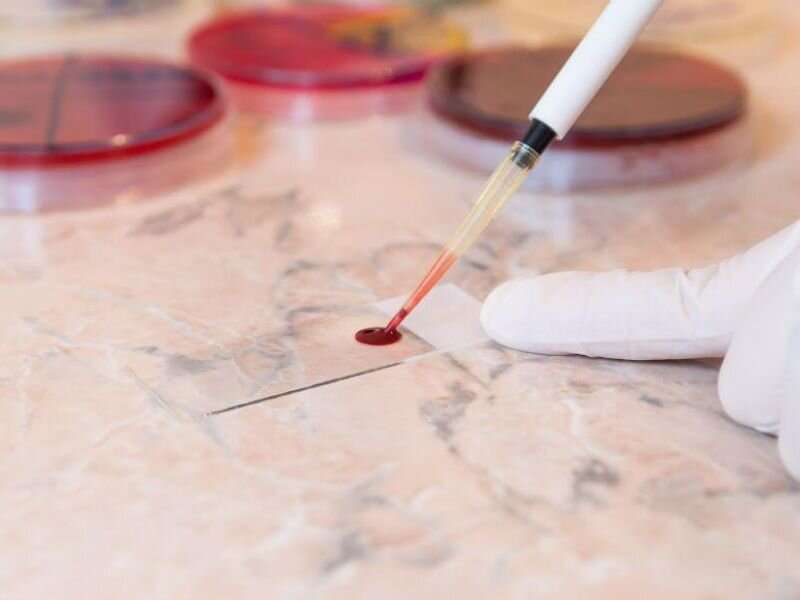
DNA fragments in blood promise cheap, easy test for cancer

-

生物通官微
陪你抓住生命科技
跳动的脉搏
血液中的DNA片段有望用于癌症的廉价、简便的检测
【字体: 大 中 小 】 时间:2023年01月19日 来源:Science Translational Medicine
研究人员正在报告一种血液测试的进展,该测试可以以一种相对简单、可能比其他正在开发的测试更便宜的方式检测多种癌症。
该测试使用一种相当直接的方法来检测血液中的某些癌症信号:计算在意想不到的地方出现“断裂”的DNA片段。
在这项新的研究中,科学家们发现这种方法可以区分11种不同类型癌症中的任何一种癌症患者和非癌症患者。不仅如此,根据麦迪逊威斯康辛大学医学和公共卫生学院的高级研究员Muhammed Murtaza博士的说法,它可以使用相对较少的血液样本。
这是相对于其他正在开发的用于癌症筛查的血液测试而言的,这些测试通常需要多管血液。
“我们的方法最大的优势可能是成本效益,”Muhammed Murtaza说,尽管他补充说,很难对现实世界的成本做出预测。
这项研究发表在1月11日的《科学转化医学》(Science Translational Medicine)杂志上,是开发可以作为多种癌症一站式筛查的血液检测的更广泛努力的最新成果之一。
许多公司正在研究这种“多种癌症”的早期检测测试。从本质上讲,它们都是基于肿瘤在血液中脱落少量遗传物质这一事实。如果一种测试可以检测出这些肿瘤信号,就可以提供一种简单、非侵入性的方法来筛查各种癌症――包括目前缺乏任何筛查方法的癌症。
Muhammed Murtaza解释说,这些测试的不同之处在于它们测量的究竟是什么。
他和他的同事们采用了分析DNA“碎片模式”的方法。肿瘤细胞和健康细胞都会定期向血液中释放DNA片段。但由于肿瘤细胞表达的基因与正常体细胞不同,它们的DNA片段断裂方式也有所不同。
Muhammed Murtaza说,这项新测试着眼于血液中DNA片段的“末端位置”,以确定断裂是否发生在“意想不到的地方”。
他将其描述为一种“简单的方法”,可以使用更小的血液样本,其中含有有限的DNA(在DNA的世界中,至少有100万个DNA片段)。
在这项研究中,研究人员分析了286名健康人群、103名非癌症患者和994名11种癌症患者的血液样本。从乳腺癌、卵巢癌到黑色素瘤,再到胆管肿瘤和致命的脑癌胶质母细胞瘤等更罕见的癌症。
总的来说,研究人员发现,该测试很好地确定了哪些血液样本来自癌症患者,包括那些患有早期癌症的患者,这在筛查测试中是很重要的。
根据研究人员的说法,该测试对癌症整体的“曲线下面积”(AUC)为0.91,对一期癌症的AUC为0.87。AUC是测试精度的度量,范围从0到1:越接近1越好。
穆尔塔扎说,还需要更多的研究。他说,接下来的一个步骤是看看该测试在检测单一癌症而不是多种癌症方面的表现如何,包括胰腺癌,一种没有筛查测试的致命疾病。
一位没有参与这项研究的研究人员也认为,与其他正在开发的血液检测相比,这种方法“可能有一些优势”。
“这是另一种可能更简单,也可能更便宜的方法,”纽约大学朗格尼分校珀尔马特癌症中心的David Polsky博士说。
和Muhammed Murtaza一样,他说这项测试“还没有准备好”,还需要更多的研究。
David Polsky说,任何旨在筛查健康人群患癌症的测试,都有一些重要的性能衡量标准:灵敏度,即测试正确识别癌症患者的能力;以及它的特异性,或者说它正确识别没有患癌症的人的能力。
Polsky指出,特异性是至关重要的,因为如果特异性太低,测试将产生大量假阳性结果,导致不必要的后续测试和焦虑。
其他一些用于癌症筛查的血液测试也在进一步开发中,其中包括一种名为Galleri的测试,它可以通过一次抽血筛查50多种癌症。目前,它正在美国多个医疗中心的探路者2号研究中进行测试。
目前美国食品和药物管理局还没有批准多种癌症早期检测测试。